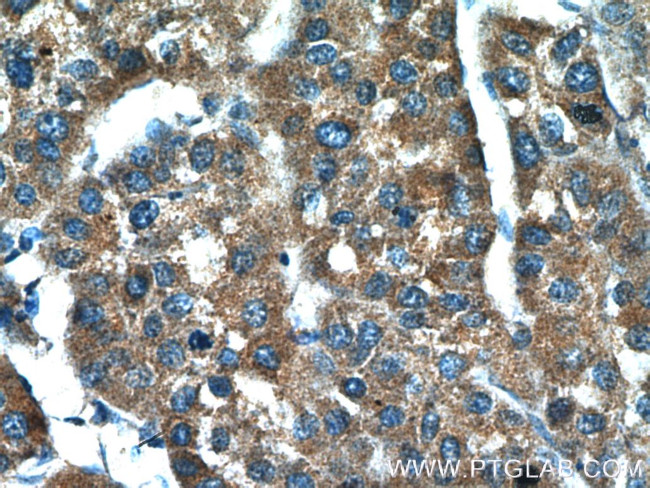
BPGM Antibody in Immunohistochemistry (Paraffin) (IHC (P))

Search
Proteintech
BPGM Polyclonal Antibody
{{$productOrderCtrl.translations['antibody.pdp.commerceCard.promotion.promotions']}}
{{$productOrderCtrl.translations['antibody.pdp.commerceCard.promotion.viewpromo']}}
{{$productOrderCtrl.translations['antibody.pdp.commerceCard.promotion.promocode']}}: {{promo.promoCode}} {{promo.promoTitle}} {{promo.promoDescription}}. {{$productOrderCtrl.translations['antibody.pdp.commerceCard.promotion.learnmore']}}
产品信息
17173-1-AP
种属反应
已发表种属
宿主/亚型
分类
类型
抗原
偶联物
形式
浓度
规格
纯化类型
保存液
内含物
保存条件
运输条件
产品详细信息
Immunogen sequence: MSKYKLIML RHGEGAWNKE NRFCSWVDQK LNSEGMEEAR NCGKQLKALN FEFDLVFTSV LNRSIHTAWL ILEELGQEWV PVESSWRLNE RHYGALIGLN REQMALNHGE EQVRLWRRSY NVTPPPIEES HPYYQEIYND RRYKVCDVPL DQLPRSESLK DVLERLLPYW NERIAPEVLR GKTILISAHG NSSRALLKHL EGISDEDIIN ITLPTGVPIL LELDENLRAV GPHQFLGDQE AIQAAIKKVE DQGKVKQAKK (1-259 aa encoded by BC017050)
靶标信息
Riboflavin kinase is an essential enzyme that catalyzes the phosphorylation of riboflavin to form flavin mononucleotide, an obligatory step in vitamin B2 utilization and flavin cofactor synthesis.
仅用于科研。不用于诊断过程。未经明确授权不得转售。
生物信息学
蛋白别名: 2,3-bisphosphoglycerate mutase, erythrocyte; 2,3-bisphosphoglycerate synthase; 2,3-diphosphoglycerate mutase; Bisphosphoglycerate mutase; BPG-dependent PGAM; BPGM; DPGM; erythrocyte 2,3-bisphosphoglycerate mutase; testis secretory sperm-binding protein Li 202a; unnamed protein product
基因别名: Ab2-098; AI323730; AL022789; BPGM; C86192; DPGM; ECYT8
UniProt ID: (Human) P07738, (Mouse) P15327
Entrez Gene ID: (Human) 669, (Rat) 296973, (Mouse) 12183